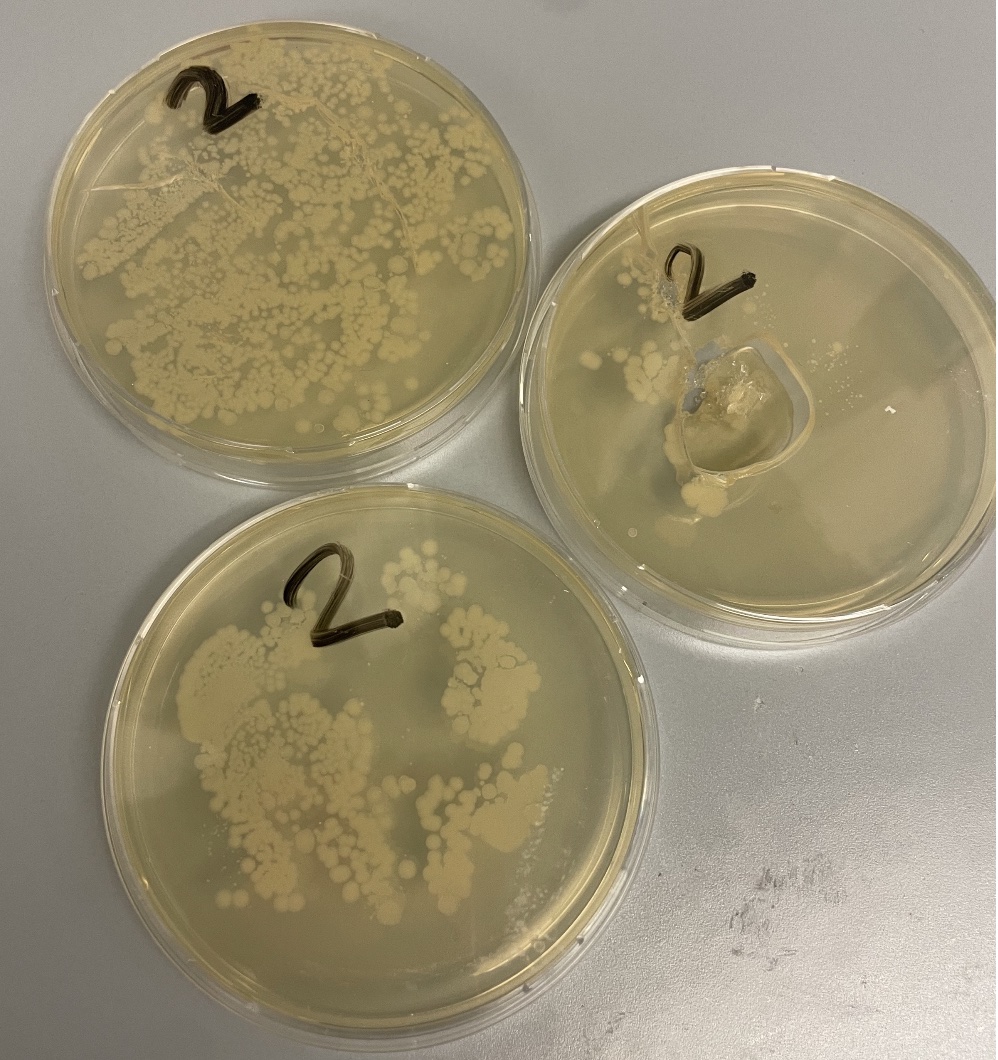

Atelier de Discussion « Voix d’Enfants »
L’objectif de l’atelier de discussion « Voix d’Enfants » est de créer un espace inclusif et respectueux où les enfants peuvent s’exprimer librement, partager leurs idées et leurs opinions, et contribuer à la construction d’un groupe où chaque voix compte.
Organisation et déroulement des Ateliers :
Les ateliers sont organisés régulièrement, avec une fréquence adaptée à la disponibilité des enfants et à la nature des sujets à discuter.
Chaque atelier est animé par un facilitateur qui encourage la participation de tous et veille au respect des règles de la discussion.
Les discussions sont structurées autour de questions ouvertes qui invitent les enfants à partager leurs expériences, leurs opinions et leurs idées.
L’écoute active est encouragée, et les enfants sont invités à respecter les points de vue des autres participants.
Les sujets abordés sont pertinents pour la vie quotidienne des enfants et visent à favoriser leur engagement et leur implication au sein du groupe.
Voici quelques exemples de discussion lors de l’atelier :
-Les activités et les projets à organiser au sein du groupe.
-Les règles et les comportements attendus.
-Les idées d’amélioration pour l’espace de jeu ou d’autres espaces communs.
-Tâches de chacun
-planning des repas et courses à faire…
Conclusion :
L’atelier de discussion « Voix d’Enfants » vise à donner aux enfants les outils et les opportunités nécessaires pour s’exprimer, écouter et contribuer à la construction d’un groupe harmonieux et démocratique. En encourageant la participation active et le respect mutuel, cet atelier contribue à renforcer le sentiment d’appartenance au sein du groupe et à développer leur sens de la citoyenneté active.
-6 enfants entre 3 et 9 ans participent à l’atelier.

Autres projets

Projet les droits de l’enfant
Les enfants ont décrit leur projet dans le document ajouté en pièce jointe. Chaque phrase, la mise en page et chaque photo, ont été...
Voir le projet
Défendre et promouvoir les droits de l’enfant
Les institutions de l’éducation non formelle jouent un rôle important dans la mise en œuvre des droits de l’enfant, ce qui est souligné par...
Voir le projet
Partager, c’est aimer
Les enfants ont réalisé de délicieux biscuits de Noël afin de les donner à leur entourage. Avec leurs éducatrices, ils ont été à la...
Voir le projet